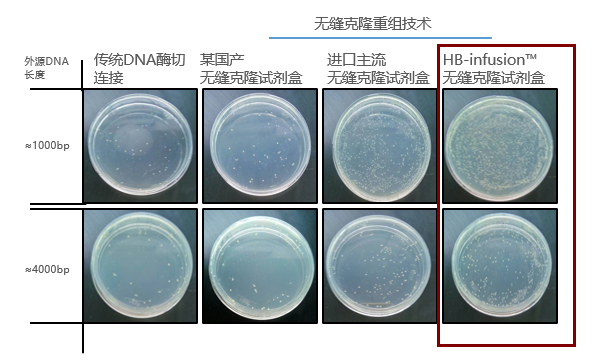

让载体构建更easy,分子克隆其实可以ze么快!
每个做过分子实验的人可能都会有这样的经历:在经过N次的PCR、酶切、连接、转化之后,阳性率依旧很低,到底是哪一步出了问题?今天就给大家详解一下可以一步法快速构建同源重组载体,并且阳性率很高的方式:无缝克隆。
无缝克隆技术是一种新的、快速、简洁的克隆方法,可以在质粒的任何位点进行一个或多个目标DNA的片断的插入,而不需要任何限制性内切酶和连接酶。突破传统的双酶切再加上连接,只需要一步重组法,即可得到高效率克隆的重组载体,大大提高了工作效率。
我们先来将传统克隆与无缝克隆做下比较:

传统克隆 | 无缝克隆 |
Ø PCR引物设计需引入载体上的酶切位点,PCR产物再经过酶切、胶回收、连接后定向克隆到目的载体上; Ø 需要查找合适的酶切位点,购买各种内切酶; Ø 阳性率低; Ø 多个片段,通常只能分多次拼接。
| Ø 只需要一次反应即可完成定向克隆,省略酶切、酶连等过程; Ø 对酶切位点无要求,可以把目的片段插入到任意载体的任意位点; Ø 连接片段之间不会引入任何其他序列; Ø 可以同时克隆多个片段。
|
无缝克隆相较于传统克隆的方式,优势显而易见,,主要体现以下几点:
1、可以不需要任何限制性内切酶、连接酶,也不需要磷酸化、末端补平等操作;
2、可同时连接多个DNA片段,最多可达10个;
3、不附加任何多余序列,精确定向连接;
4、体系反应时间仅需20min,快速反应。
那无缝克隆到底应该怎么做呢?下面我们就来详细了解下无缝克隆其原理:
在基因克隆的引物设计及目的DNA片段的扩增阶段,与常规PCR法是相同的。唯一的差异在于载体末端和引物末端应具有15-20个同源碱基,由此得到的PCR产物两端便分别带上了15-20个与载体序列同源性的碱基。

图1:无缝克隆原理图
在用无缝克隆方式进行分子克隆时,主要操作步骤分为以下3点:
1、线性化目的载体(图1左上):用酶切或是PCR方式
1)质粒酶切法
在目标载体质粒上选取合适的位点进行单酶切或双酶切,对酶切后的载体进行割胶纯化。
2)质粒PCR法
如果没有合适的酶切位点,你也可以通过PCR方法实现载体的线性化。

图2.PCR法线性化载体示意图。在插入位点两侧设计一对方向相反的引物对载体进行扩增,通过跑胶回收获取线性化载体片段
2、PCR获取目的片段。设计的引物5’端需要和线性化载体末端有15~25bp的重叠(图中蓝色和黄色片段);

图3:目的片段同源的引物设计
针对双酶切法线性化载体设计插入片段的PCR 引物,其重叠区域为15~25 bp+酶切位点,这样重组成功的质粒上会完好保留此两个酶切位点。如果是PCR 法线性化载体,扩增插入片段的PCR引物5’端直接设计成与线性化载体末端15~25 bp 重叠即可。
3、按照一定比例把二者混合在HB-infusion™(无缝克隆试剂盒)的2×预混液内,50℃反应20min后直接转化E.coli即可。
反应体系如下:

通过以上三步,就可以完成质粒重组。只要再进行后续的转化感受态等操作,就可以完成载体构建。
当然,这么简单高效的分子克隆方式, 怎么能少了汉恒生物的HB-infusionTM无缝克隆试剂盒呢!
无论你是要做简单的克隆,还是多片段克隆或者突变体克隆,包括载体改造和crispr载体构建等都可以用到汉恒生物的无缝克隆试剂盒。
汉恒实例分享一:小片段(1kb)和大片段(4kb)基因克隆比较
汉恒实例分享二:6个片段克隆比较

- 浏览 6113 次




